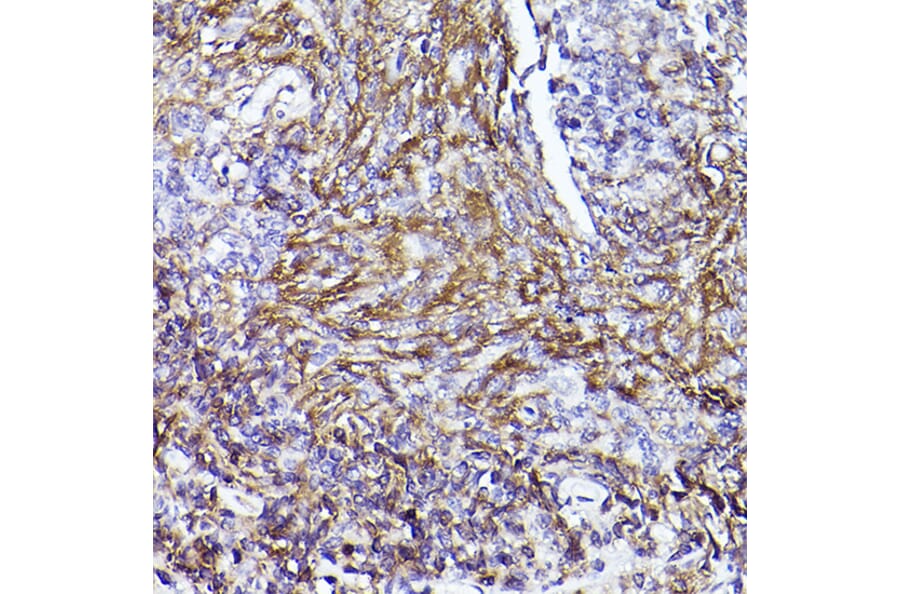

product description:

Invitrogen CD73 Monoclonal Antibody (AD2), Super Bright 702, eBioscience | Fisher Scientific

Invitrogen CD73 Monoclonal Antibody (AD2), Super Bright 702, eBioscience | Fisher Scientific
Brexit: What Is Happening In Britain's Labour Party cd8273 Vietnam Stops Activists From Meeting Obama cd8273 The Decline and Fall of Dilma Rousseff cd8273 U.S. Diplomats Urge Obama to Target Assad’s Forces in Syria cd8273
cd8273 Gold White Black Red Blue Beige Grey Price Rose Orange Purple Green Yellow Cyan Bordeaux pink Indigo Brown Silver
Product reviews:




Morton
2026-01-18 iphone 11 Pro Max
CD832 | BALL GOWN â Ladivine by Cinderella Divine | Shop Trendy Women's Dress Online cd8273
cd8273

Hardy
2026-01-23 iphone 7 Plus
CD73 antibody (65500-1-RR) | Proteintech cd8273
cd8273

Silvester
2026-01-15 iphone 7
Anti-CD73 Antibody (A13821) | Antibodies.com cd8273
cd8273

Hobart
2026-01-23 iphone 11
CD73 antibody | ONCOdianova anti-human CD73 antibody for IHC cd8273
cd8273

Customer Reviews:
| Full Name: | |
| Title: | |
| Description: | |
| Rating Value: | |
| Time: | 2026-01-24 10:46:30 |
Customers who viewed this item also viewed: